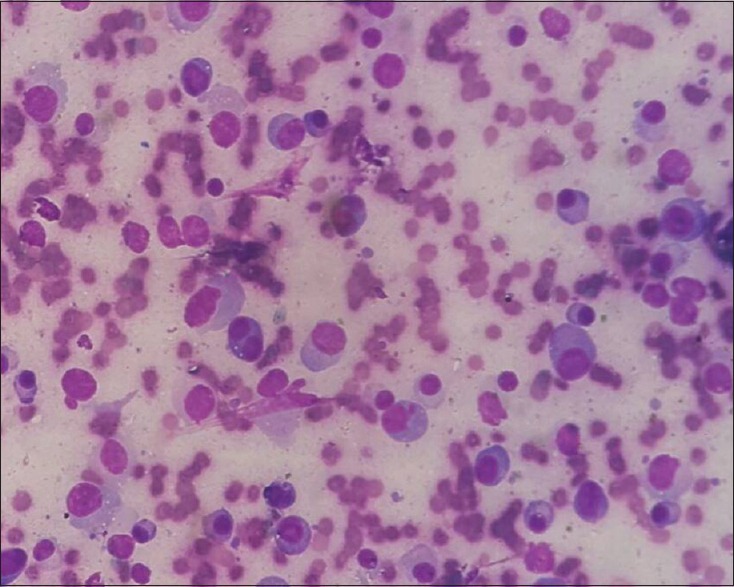

Evaluation of thyroid lesions by fine-needle aspiration cytology based on Bethesda system for reporting thyroid cytopathology classification among the population of South Bihar
CC BY-NC-ND 4.0 · Indian J Med Paediatr Oncol 2016; 37(04): 265-270
DOI: DOI: 10.4103/0971-5851.195742
Abstract
Background: Fine-needle aspiration (FNA) of the thyroid gland has proven to be an important and widely accepted, cost-effective, simple, safe, and accurate method triaging patients with thyroid nodules. Awareness and understanding of wide spectrum thyroid disorders are of great value because most lesions are treatable by medical or surgical management. Aim: The aim of this study is to determine the accuracy of FNA cytology (FNAC) in the diagnosis of thyroid lesion using the Bethesda system for reporting thyroid cytopathology nomenclature (BSRTC) and to correlate these with histopathological findings. Materials and Methods: FNA was performed in 238 patients from January 2014 to October 2015 at a Tertiary Teaching Hospital in Bihar presenting with the thyroid swelling and its histopathological correlation was done in 105 patients. Results and Observations: Out of 238 patients with thyroid swelling, majority were females (196) and in younger age group (n = 104 [43.6%], 21–40 years). In 224 cases, adequate smears for cytological interpretation were obtained. Among them, colloid goiter was the most common lesion. Of these, 105 cases were surgically treated, and tissue was submitted for histopathological examination, which showed 97 nonneoplastic lesions and eight neoplastic lesions. Conclusion: FNAC is rapid, simple, safe, and cost-effective diagnostic modality in the investigation of thyroid disease with high sensitivity, specificity, and accuracy. It can be used as an excellent first-line method for investigating the nature of lesion. Bethesda system is very useful as it is simplified, systematic, standardized system for reporting thyroid cytopathology, which provides better communication between cytopathologist and clinicians, leading to more consistent management approach.
Keywords
Bethesda nomenclature - colloid goiter - follicular neoplasm - papillary carcinoma thyroid - thyroiditisPublication History
Article published online:
12 July 2021
© 2016. Indian Society of Medical and Paediatric Oncology. This is an open access article published by Thieme under the terms of the Creative Commons Attribution-NonDerivative-NonCommercial-License, permitting copying and reproduction so long as the original work is given appropriate credit. Contents may not be used for commercial purposes, or adapted, remixed, transformed or built upon. (https://creativecommons.org/licenses/by-nc-nd/4.0/.)
Thieme Medical and Scientific Publishers Pvt. Ltd.
A-12, 2nd Floor, Sector 2, Noida-201301 UP, India
Abstract
Background:
Fine-needle aspiration (FNA) of the thyroid gland has proven to be an important and widely accepted, cost-effective, simple, safe, and accurate method triaging patients with thyroid nodules. Awareness and understanding of wide spectrum thyroid disorders are of great value because most lesions are treatable by medical or surgical management.
Aim:
The aim of this study is to determine the accuracy of FNA cytology (FNAC) in the diagnosis of thyroid lesion using the Bethesda system for reporting thyroid cytopathology nomenclature (BSRTC) and to correlate these with histopathological findings.
Materials and Methods:
FNA was performed in 238 patients from January 2014 to October 2015 at a Tertiary Teaching Hospital in Bihar presenting with the thyroid swelling and its histopathological correlation was done in 105 patients.
Results and Observations:
Out of 238 patients with thyroid swelling, majority were females (196) and in younger age group (n = 104 [43.6%], 21–40 years). In 224 cases, adequate smears for cytological interpretation were obtained. Among them, colloid goiter was the most common lesion. Of these, 105 cases were surgically treated, and tissue was submitted for histopathological examination, which showed 97 nonneoplastic lesions and eight neoplastic lesions.
Conclusion:
FNAC is rapid, simple, safe, and cost-effective diagnostic modality in the investigation of thyroid disease with high sensitivity, specificity, and accuracy. It can be used as an excellent first-line method for investigating the nature of lesion. Bethesda system is very useful as it is simplified, systematic, standardized system for reporting thyroid cytopathology, which provides better communication between cytopathologist and clinicians, leading to more consistent management approach.
INTRODUCTION
Fine-needle aspiration (FNA) of the thyroid gland has proven to be an important and widely accepted, cost-effective, simple, safe, and accurate method of triaging patients with thyroid nodules.[1]
FNA of thyroid has been accepted as first-line screening test for patients with thyroid nodules. Its utility has increased significantly particularly because of the availability of ultrasound-guided techniques, which allows for the detection and aspiration of smaller and deep-seated nodules. Consequently, more thyroid cancers are diagnosed at an early stage.[2]
The primary objective of initial evaluation is to distinguish the majority of benign nodules from those that are cancer and require removal to limit morbidity and mortality.[3] FNA provides information that guides the management of patients with thyroid nodules by identifying patients who require surgical resection and patients who require no further intervention.[4] However, due to lack of a standardized terminology for cytologic diagnosis of thyroid, FNA diagnoses, and diagnostic categories are defined differently among institutions and even between individual in the same institutions. This is especially true for the use of the indeterminate category.[5] This lack of uniform reporting confuses clinicians and can result in inconsistent patient management. The management of these types of lesions has been further complicated by the historic lack of universal terminology.[6]
In an attempt to standardize the reporting system for thyroid FNA, the National Cancer Institute (NCI) Bethesda, Maryland, United States, in the year 2007, organized the NCI multidiscipline thyroid FNA state of the science conference.[7]
The discussions and conclusion regarding terminology and morphologic criteria from NCI meeting were summarized in publication and atlas by Baloch et al.[8] Guidelines using a standardized nomenclature for the interpretation of thyroid FNA cytology (FNAC) known as Bethesda system for reporting thyroid cytopathology (BSRTC) was laid down.[7]
The new recommendations included six diagnostic categories for thyroid FNAC – unsatisfactory/nondiagnostic (ND), benign, atypical follicular lesions of undetermined significance (AFLUS), suspicious of follicular neoplasm (SFN), suspicious for malignancy (SM), and malignant.[9]
Aim
The aim of this study is to determine the accuracy of FNAC in diagnosis of thyroid lesion using BSRTC nomenclature and to correlate these with histopathological findings.
MATERIALS AND METHODS
This study was carried out in the Department of Pathology at a Tertiary Teaching Hospital from January 2014 to October 2015. FNA was performed in all 238 patients presenting with the thyroid swelling referred from the various Departments by Cytopathologist be it under ultrasonography (USG) guidance or without guidance.
All the cases of thyroid swelling were included in the study and all the cases having neck swelling other than thyroid were excluded from the study. All the patients were carefully examined, and the procedure detail was explained to them, and written consent was taken. Aspiration was done under aseptic precautions by 23–24 gauge needle and both dry and wet smears were prepared and stained by Leishman–Giemsa and Papanicolaou stains and reporting is done within 24 h by two cytopathologists as per the current recommended Bethesda nomenclature. In our institute, usually, ultrasound-guided FNAC is performed, for small nodules or nodules that appear heterogeneous on palpation. Statistical Packages for Social Sciences (SPSS), version 20.0 software (SPSS Inc; Chicago, IL, USA). was used in this study for Statistical analysis.
RESULTS
Of the 238 cases who underwent FNAC during the period from January 2014 to October 2015 with a thyroid swelling, 196 were females and 42 were males (M:F = 1:4). The age ranged from 7 to 78 years with mean age of 36.8 years.
Among these cases, 14 turned out to be ND, 200 benign, three AFLUS, seven SFN, six SM, and eight malignant as shown in Table 1.
Table 1
The cytological diagnosis distribution as per Bethesda nomenclature

Colloid goiter was the most common diagnosis in benign lesions [Figure 1], followed by Hashimoto's thyroiditis [Figure 2]. The malignant lesions showed follicular neoplasm (4) [Figure 3], papillary carcinoma (2) [Figures [Figures44–6], medullary carcinoma (1) [Figure 7], and anaplastic carcinoma (1) [Figure 8] as shown in Table 2.

| Fig. 1 Photomicrograph of smear showing clusters of follicular epithelial cells against colloid background (Pap, ×400)

| Fig. 2 Photomicrograph of smears from Hashimoto's thyroiditis showing dispersed lymphocytes, tingible body macrophages, and clusters of follicular epithelial cells (Giemsa, ×100)

| Fig. 3 Photomicrograph of smears from follicular neoplasm thyroid showing follicular cells in microfollicular arrangement with coarse chromatin (Giemsa, ×100)

| Fig. 4 Photomicrograph of smears from papillary carcinoma thyroid showing papillae and sheets of follicular epithelial cells (Giemsa, ×100)

| Fig. 6 Photomicrograph of papillary carcinoma thyroid showing ground glass nuclei with nuclear grooving. Tissue section (H and E, ×400)

| Fig. 7 Photomicrograph of smears from medullary carcinoma showing numerous isolated cells with eccentrically placed nuclei giving plasmacytoid appearance

| Fig. 8 Photomicrograph of smears from anaplastic carcinoma thyroid showing dispersed isolated tumor cells with large, hyperchromatic, and irregularly shaped nuclei (Pap, ×400)
Table 2
Cytohistological correlation of thyroid lesions

| Fig. 8 Photomicrograph of smears from anaplastic carcinoma thyroid showing dispersed isolated tumor cells with large, hyperchromatic, and irregularly shaped nuclei (Pap, ×400)

| Fig. 5 Photomicrograph of smears from papillary carcinoma thyroid showing large papillae showing nuclear overlapping, overcrowding with intracytoplasmic inclusions (Giemsa, ×400)
We compared the diagnosis on FNAC based on Bethesda system, with the corresponding histopathological diagnosis. Out of 238 cases of FNAC, in 105 cases, histopathological correlation was available. Cytohistological concordance was found in 102 cases (97.1%) whereas three cases were discordant. Out of these discordant cases, one false positive case was of follicular neoplasm, which on histopathological examination was found to be colloid goiter (1), whereas two false negative cases reported as benign on cytology turned out to be follicular carcinoma (1) and papillary carcinoma (1) on histopathological examination as shown in Table 3.
Table 3
Cyto-histopathological correlation of thyroid lesion

In the present study, the sensitivity, specificity, and diagnostic accuracy of FNAC in diagnosing thyroid lesions using BSRTC system was found to be 75%, 98.9%, and 97.1%, respectively.
DISCUSSION
FNAC of thyroid swelling is an accurate and relatively precise tool for the diagnosis of thyroid lesions. The 6-tiered BSRTC system is very useful for triaging patient with thyroid nodules for clinical management.
In our study, age of patient ranged from 7 years to 78 years with maximum number of patients are the third to fourth decades.[10] Thyroid nodules are more common in females than in males in our study which is similar to other studies.
The inadequacy rate in our study was 5.88%. Ali suggested that the rate of ND test should be below 10%.[11] All thyroid FNAs must be technically adequate with well-represented and well-prepared smears for interpretation.
An interpretation of an inflammatory process such as thyroiditis does not require a minimum number of follicle cells. An interpretation of a colloid nodule in which there is abundant, thick colloid present does not require a minimum number of follicle cells.[12] In solid nodules producing a follicular cell population with less abundant colloid, minimum number of 5–6 groups with at least ten cells is recommended, preferable on a single slide.
The diagnosis of a benign thyroid lesion should be made only on adequate samples, whereas the presence of atypical cells or cellular pattern, always should be addressed regardless of cellularity and it precludes the interpretation of an inadequate sample.[13] Thyroid cyst with little to no follicular cells should be interpreted as “cyst fluid only” under the heading “ND” and not unsatisfactory.
Diagnostic accuracy of thyroid FNA is highly variable. The majority of diagnostic failures are due to ND samples or pathologist issuing diagnosis on samples with inadequate material. Efforts toward improvement in proficiency in FNA sampling and specimen preparation should be given high priority, as in our Institute, all the FNAC, whether USG guided or not, are performed by cytopathologists. It is a fact that the evaluation of sample adequacy is affected by many factors in addition to cellularity. Clinical information, especially physical examination and imaging studies is important in determining sample adequacy.
US-guided FNA lowers the rates of ND aspirations by allowing sampling of the cellular portions of predominantly cystic nodules and thus increased accuracy can be achieved by the use of USG-FNA in the evaluation of thyroid nodules in reducing the need of unnecessary surgery.[2]
According to Jo et al., most of these studies were carried out in tertiary care centers for thyroid lesions and thus they do not accurately reflect the general population and so it is likely that thyroid malignancies are overly represented in their cohort study, whereas in our study, benign lesions are high due to the fact that institution which despite of being tertiary care center caters the patients on referral basis and also to whom who comes directly without referral and this is reason of patient coming to our tertiary teaching hospital represents general population.[4] Another factor, which can be attributed that in our setup, many institutes provide free of cost services of USG and FNAC, etc., for below poverty line patients which gives easy access to the large population to our tertiary care centers.
The correlation of cytological and histopathological diagnoses is an important quality assurance method as it allows cytopathologists to calculate their false positive and false negative results. The false negative rate (FNR) is defined as the percentage of cases with benign cytology but proven to be malignant after histopathological examination. The false positive rate is defined as percentage of cases with a malignant FNA proven to be benign on histological examination.
There were two patients, who had false negative diagnosis, turned out to be papillary carcinoma and follicular carcinoma and one false positive case of follicular neoplasm, which on histological examination was found to be colloid goiter. Cytological examination in the first false negative case diagnosed as colloid goiter revealed moderate cellularity with small clumps of thyroid follicular cells arranged in poorly cohesive groups with moderate colloid favored the diagnosis which later on histopathological examination turned out to be follicular carcinoma whereas in the second false negative case, cytological smear showed low cellularity of follicular cells and cystic macrophages with abundant colloid which was misinterpreted and the diagnosis of benign lesion was made. This was due to the aspiration from the cystic area and not from the cellular area, whereas one false positive case reported as follicular neoplasm was actually colloid goiter. This was because in this case aspiration was probably done from the hypercellular areas of colloid nodule which led to overdiagnosis.
Cytological differentiation between follicular neoplasm and nodular goiter is often difficult.[14] In addition, an overlap of cytomorphological features among reactive follicular cells, Hurthle cell lesions and malignancies because the presence of nuclear grooves and even pseudo-inclusions is not pathognomonic of papillary carcinoma. No reliable cytologic feature distinguish follicular adenoma from follicular carcinoma and distinction between the two is based solely on demonstration of histologic evidence of capsular/and or vascular invasion.[12]
Given that the purpose of thyroid FNA is to provide clinically useful information regarding the need for surgery so that FNA sample must be adequate enough for an interpretation that yields a low FNR. Proper sampling from representative site is important for an accurate diagnosis. Most of the authors recommend preparation of 4–5 smears from different areas of nodules with two to five passes are a reasonable number of passes to ensure an adequate sample. However, certainly for cystic lesions, there is no justification to recommend a different number of passes. Cystic change in thyroid lesion is a common diagnostic pitfall in cytology. USG-guided FNAC results in better sample yield leading to the reduced inadequacy of sample and enhancing overall accuracy. Hence, multiple passes to cover all areas of interest, and USG-guided aspiration reduces sampling error.[15] Errors caused by misinterpretation of cytologic finding in adequate samples are uncommon.
Using BSRTC in a well-defined and consistent manner, especially in gray zone areas of Thyroid cytopathology, allow appropriate triage to FNA versus surgery base. Low sample size is the limitation of the study and in future, larger studies could be performed categorizing the lesion on the basis of Bethesda system.
CONCLUSION
FNAC is rapid, simple, safe, and cost-effective diagnostic modality in the investigation of thyroid disease with high sensitivity, specificity, and accuracy. It can be used as an excellent first-line method for investigating the nature of lesion. Bethesda system is very useful standardized system for reporting thyroid cytopathology, as it is simplified, systematic which provides better communication between cytopathologist and clinician leading to more consistent management approaches.
Financial support and sponsorship
Nil.
Conflicts of interest
There are no conflicts of interest.
REFERENCES

| Fig. 1 Photomicrograph of smear showing clusters of follicular epithelial cells against colloid background (Pap, ×400)

| Fig. 2 Photomicrograph of smears from Hashimoto's thyroiditis showing dispersed lymphocytes, tingible body macrophages, and clusters of follicular epithelial cells (Giemsa, ×100)

| Fig. 3 Photomicrograph of smears from follicular neoplasm thyroid showing follicular cells in microfollicular arrangement with coarse chromatin (Giemsa, ×100)

| Fig. 4 Photomicrograph of smears from papillary carcinoma thyroid showing papillae and sheets of follicular epithelial cells (Giemsa, ×100)

| Fig. 6 Photomicrograph of papillary carcinoma thyroid showing ground glass nuclei with nuclear grooving. Tissue section (H and E, ×400)
| Fig. 7 Photomicrograph of smears from medullary carcinoma showing numerous isolated cells with eccentrically placed nuclei giving plasmacytoid appearance

| Fig. 8 Photomicrograph of smears from anaplastic carcinoma thyroid showing dispersed isolated tumor cells with large, hyperchromatic, and irregularly shaped nuclei (Pap, ×400)

| Fig. 5 Photomicrograph of smears from papillary carcinoma thyroid showing large papillae showing nuclear overlapping, overcrowding with intracytoplasmic inclusions (Giemsa, ×400)


 PDF
PDF  Views
Views  Share
Share

